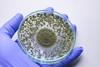
fungi-contamination-aspergillus

All Mould contamination articles
-
 News
NewsUV contamination control robot shows pharma cleanroom promise
Efficacy research supports the widespread use of autonomous UVC disinfection for microbial surface decontamination, say AstraZeneca microbiology experts.
-
 Report
ReportPharma Horizons: environmental monitoring
This exclusive report addresses the key obstacles and innovations shaping pharmaceutical environmental monitoring, from QC and contamination control, to the impact of advanced technologies and regulatory changes. Discover practical solutions you can implement to drive progress for your organisation.
-
 News
NewsMould study highlights safer far-UVC light cleaning alternative
Research suggests that to prevent common mould growth, low-dose far-UVC light could be applied as a chemical-free addition to manual cleaning of indoor surfaces.
-
Whitepaper
Whitepaper: The value and benefits of rapid mold detection in the pharmaceutical industry
Address the importance of accurate microbial identifications and proper contamination control for effective mold remediation.
-
 Whitepaper
WhitepaperProduct hub: Rapid mold detection in as little as one day
Quick to spread and difficult to detect, molds can compromise a facility in the time it takes to confirm their presence. The RMBNucleusTM Mold Alarm signals at the first sign of mold detection.
-
 Article
ArticleQA/QC & Microbiology In-Depth Focus 2023
This microbiology in-depth focus, explores sterility and bioburden testing considerations for cell and gene therapies.
-
News
NewsIdentifying origin of fungi in cleanrooms
Microbiology expert Tim Sandle’s recent video examined identifying the origin of fungi in pharmaceutical cleanrooms.
-
 News
NewsPDA releases contamination control strategy report
Technical Report 90: Contamination Control Strategy Development has been released by the Parenteral Drug Association (PDA).
-
 News
NewsLimiting microbial hazards in inhaled cannabis products
FDA researchers found there was some reduction in microbial counts by heating cannabis with a commercial vaporiser to limit microbial contamination, but they were not statistically significant.



